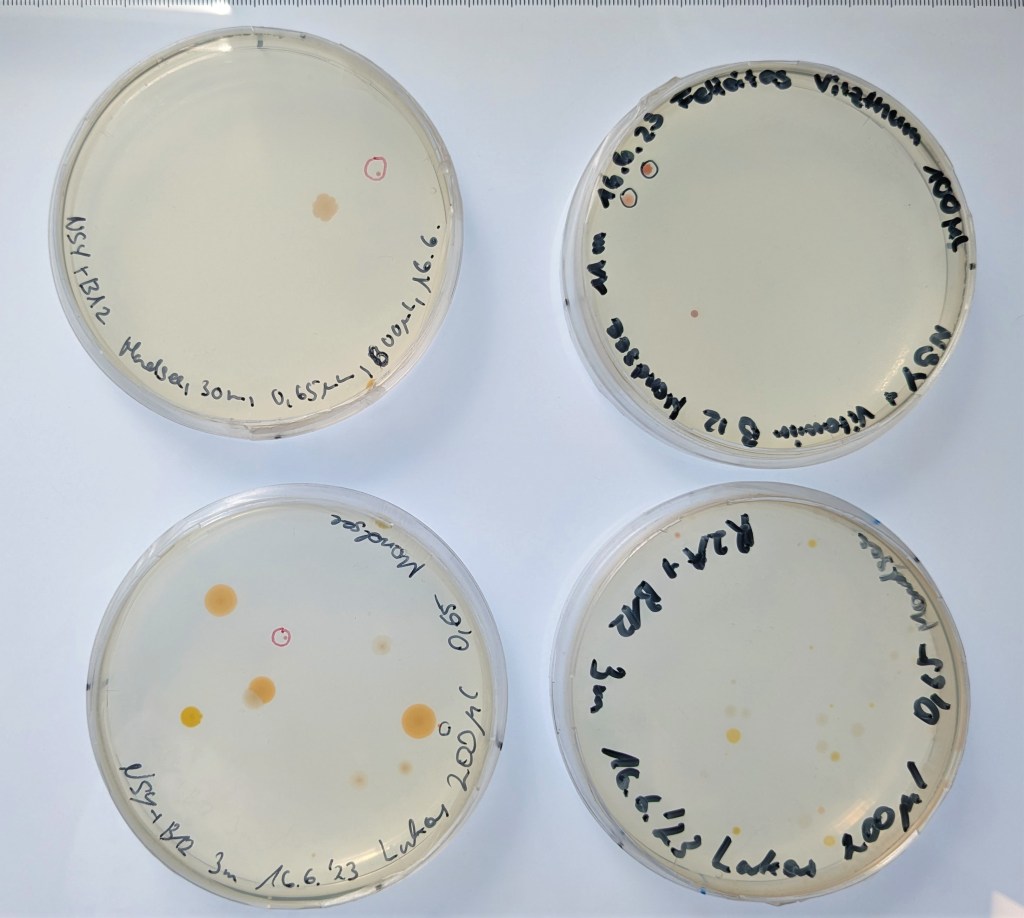

Mitarbeit am Projekt in Mondsee


Im Forschungsinstitut für Limnologie, Mondsee werden Workshops für Bügerinnen und Bürger stattfinden, die sich für das Projekt Aquirufa: Biodiversität und Ökologie von Gewässerbakterien interessieren. Es gibt Spannendes über das verborgene Leben der Bakterien im Mondsee zu erfahren und erforschen und vielleicht entdecken wir sogar neue, noch unbekannte Arten.
Wir werden gemeinsam Wasserproben aus dem Mondsee nehmen und Messungen durchführen. Anschließend werden wir die Proben im Übungslabor des Institutes bearbeiten. Dabei sollen die Teilnehmer/innen einen Einblick in das wissenschaftliche Arbeiten mit Gewässerbakterien bekommen und selbst aktiv mitarbeiten. Keine Sorge, das ist gar nicht schwer 🙂 . Es sind keine Vorkenntnisse nötig und ab ca. 15 Jahren geeignet. Kinder ab ca. 12 Jahren können auch gerne mit einem Erwachsenen gemeinsam teilnehmen. Wer mag, kann nach vorheriger Absprache auch eine Probe aus einem Gewässer (z.B. einem Gartenteich) mitbringen.
Das Institut ist von Salzburg aus sehr gut mit dem Postbus 140 zu erreichen, es stehen auch ein paar Parkplätze zur Verfügung. Weitere Informationen per email unter: Alexandra.Pitt@uibk.ac.at
1. Veranstaltung am Mondsee
Am 16.6.2023 hatten wir unsere erste Veranstaltung in unserem Forschungsinstitut am Mondsee. Sabrina Pitt hatte im Rahmen einer Lehrveranstaltung der PH Salzburg zum Workshop ‚Forschung trifft Gesellschaft‘ eingeladen. zum ganzen Beitrag

2. Aquirufa Kulturen aus dem Mondsee
Auf den Agarplatten, die mit Mondseewasser aus verschiedenen Tiefen behandelt wurden, haben wir schon einige typisch rote Kolonien entdeckt, z.B. aus 3m Tiefe (Lukas Moravec) und auch aus 11m Tiefe (Felicitas Vitzthum). Eine Kultur konnten wir schon gewinnen, es ist ein Stamm von Aquirufa antheringensis.
3. Zweite Veranstaltung am Mondsee
Am 8.9.2023 hatten wir wieder Gäste bei uns am Institut. Die kleine, aber sehr nette Gruppe machte sich bei herrlichem Wetter mit uns auf zur Probenahme am Mondsee. zum ganzen Beitrag

4. Winterprobenahme am Mondsee

Bei herrlichem Sonnenschein starteten wir unsere Winterprobenahme am Mondsee. Begleitet wurden wir von Sabrina und Daniela, die tatkräftig mithalfen. zum ganzen Beitrag
5. Sommerprobenahme am Mondsee
Bei herrlichem Wetter haben wir unsere Sommerprobenahmen am Mondsee durchgeführt. Mit dabei waren unsere drei Praktikant/innen Hannah, Sophia und Thomas hier gehts zum Beitrag
